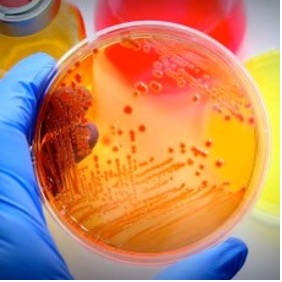

History
The Center for Food Animal Health, Food Safety and Food Defense (CFAFSD) in the Tuskegee University College of Veterinary Medicine (TUCVM) was conceived and initiated by Dean Ruby Perry in March, 2019, with a goal of improving Food Animal Health, Food Safety and Food Defense in the State of Alabama. The Center would play a significant role in supporting Alabama`s Agriculture.
Collaboration
TU Faculty in the Department of Pathobiology, Large Animal Clinical Sciences, Biomedical Sciences as well as faculty of Animal Sciences in the CAENS will play a major role in all activities of the Center. The Center scientists will collaborate with experts at other institutions including:
- USDA ARS Laboratories in Athens, GA and Auburn, AL
- Korea Research Institute of Bioscience and Biotechnology (KRIBB), Seoul, Korea
- Nano-Biosensor laboratory at Michigan State University, East Lansing, MI
- Research Institute for Biotechnology and Environment, University and Long Lam, Ho Chi Minh, Vietnam.
Research,Teaching & Training

- Teach and conduct cutting edge research in food animal diseases, trans boundary and zoonotic animal diseases, and pre-harvest and post-harvest food safety
- Train International fellows in different food safety and food animal disease diagnostics
- Provide summer training opportunities for DVM students with interest in food animal health and food safety
- Cooperate with the state offices to develop opportunities for advancement of agricultural food safety in Alabama
Different food safety and food animal disease
 |
 |
 |
 |
Diagnostic Service
- Provide microbiological diagnostic service to TUCVM veterinary teaching hospital and to food animal farms served by TUSVM
- Improve capabilities and infrastructure for the diagnosis of food animal diseases by using advanced state-of-the-art genetic and molecular technologies
- Provide superior diagnostic services using in-house developed and patented molecular foodborne pathogen detection tools that can be availed by private food industry on payment basis.

Location:
College of Veterinary Medicine
Williams Bowie Hall Room #2038
Montgomery Rd
Tuskegee, AL36088